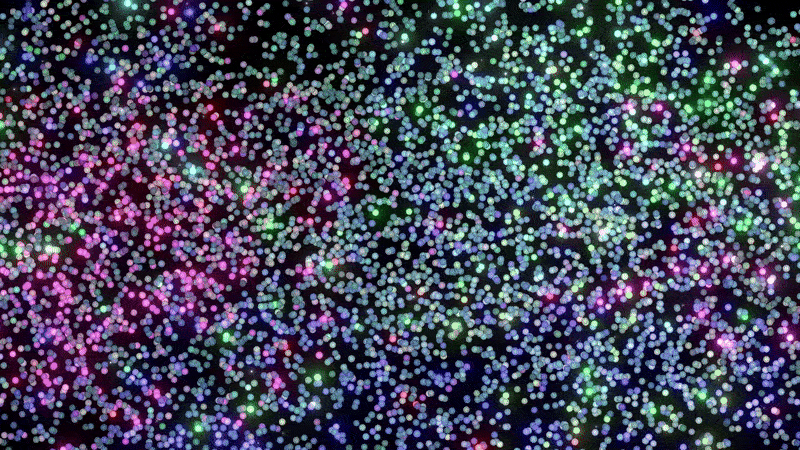

IMMERSIVE GALLERY DUBAI - The Trip of the Fool
You may also like

Mugler Alien Parfume - Klarens Interpretation
2024

SOT - 3D ANIMATION MUSIC VIDEO
2024

Frank Ocean - NIGHTS / VISUALS
2020

KLARENS - YEAR 4 OF EVERYDAYS
2022

KLARENS - YEAR 3 OF EVERYDAYS
2020

Ardbeg Vintage Y2K Campaign
2025

DIGITAL RENAISSANCE
2022

Rick and Morty Fan Art
2019

AFTER HOURS - Short Film
2022

SUSPIRIUM - Visuals by Klarens
2023